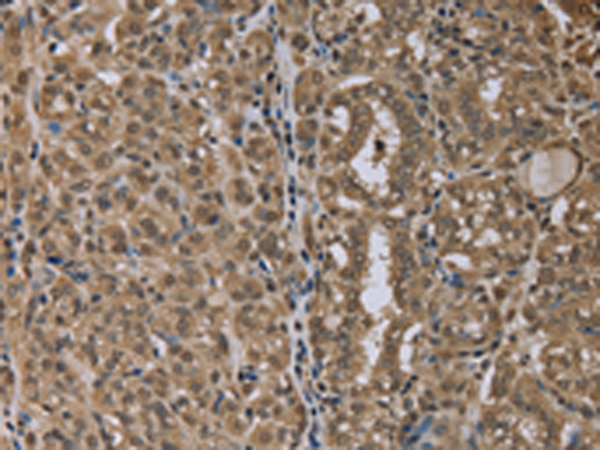
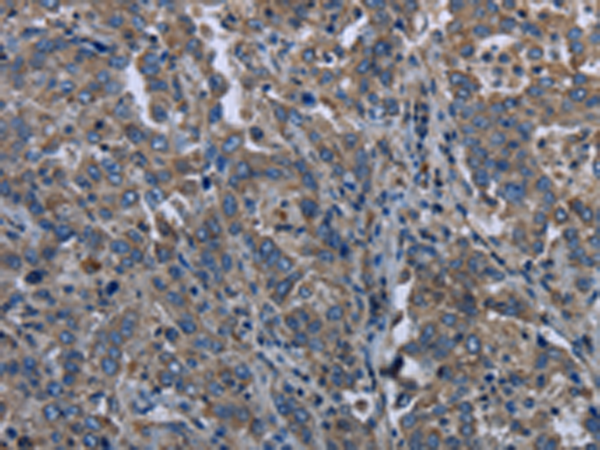

-
分类: 科研抗体货号: P11950别名: AI2A2; MMP-20应用: WB,IHC反应种属: Human, Mouse
-
分类: 科研抗体货号: P11929别名: MARK4L; MARK4S; MARKL1; PAR-1D; MARKL1L应用: IHC反应种属: Human, Mouse
-
分类: 科研抗体货号: P11966别名: AVR; NAVR; PAN3; NALP6; PYPAF5; CLR11.4; NAVR/AVR应用: IHC反应种属: Human
-
分类: 科研抗体货号: P11949别名: MLK3; PTK1; SPRK; MLK-3; MEKK11应用: WB,IHC反应种属: Human, Mouse, Rat
-
分类: 科研抗体货号: P11927别名: MK2; MK-2; MAPKAP-K2应用: WB,IHC反应种属: Human, Mouse
-
分类: 科研抗体货号: P11965别名: CT58; PAN2; RNH2; NALP4; PYPAF4; CLR19.5应用: IHC反应种属: Human
-
分类: 科研抗体货号: P11948别名: MIP; TRN; IPO2; MIP1; KPNB2应用: IHC反应种属: Human, Mouse
-
分类: 科研抗体货号: P11924别名: PWLS; nM15; NDNL1; SHFYNG应用: WB反应种属: Human
-
分类: 科研抗体货号: P11946别名: MIG6; RALT; MIG-6; GENE-33应用: WB,IHC反应种属: Human, Mouse
-
分类: 科研抗体货号: P11964别名:应用: IHC反应种属: Human

鄂公网安备42018502007531号
鄂公网安备42018502007531号

